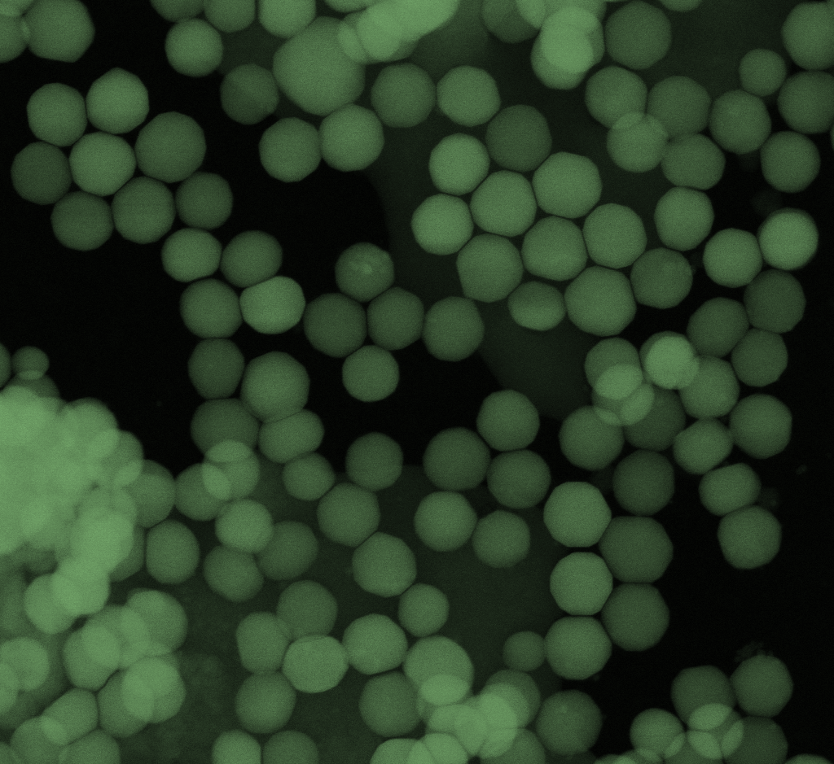

Welcome to Eluceda
Eluceda is a detection technology business that delivers powerful solutions for a wide range of applications including product & brand authentication, biological & chemical testing, and in vitro diagnostics.
Our mission is to make the world a safer place by delivering quicker, cheaper, and more portable testing technologies, that provide laboratory-level accuracy at the point of use.
Product & Brand Authentication
Complete customisable brand protection solutions from covert markers through to forensic in-field detection.

Biological & Chemical Testing
Fast and quantitative detection of bacteria, or indeed any DNA, and chemicals down to extremely low levels.

In Vitro Diagnostics
Rapid detection of pathogens, including Viruses, for in-field, point of use screening applications.
Eluceda's Latest News
Eluceda is proud to announce that its Knowledge Transfer Partnership (KTP) with the University of Leeds has been awarded a Certificate of Excellence, rated “Outstanding” , by Innovate UK . The KTP, led by Associate Dr Tarun Kakkar , centred on the development of NanoTagg TM - a pioneering upconverting nanophosphor (UCNP) technology for product authentication and brand protection. NanoTagg TM harnesses the unique optical properties of UCNPs to create highly secure, tamper-proof tagging solutions . This represents a significant step forward in combating the growing global problem of counterfeit products, with applications spanning banknotes, tax stamps, legal documents, beverages, and luxury goods . Matthew Harte, CEO of Eluceda, commented: “We are honoured that our collaboration with the University of Leeds has been recognised by Innovate UK with this award of excellence. The development of NanoTagg demonstrates the power of industry–academic partnerships in driving meaningful innovation. Counterfeit products are a global challenge, and NanoTagg TM offers a novel, commercially viable solution with the potential to transform product security and brand protection across multiple sectors. We expect to see significant growth for this product over the next 24 months” This recognition underscores the technical innovation, impact potential, and commercial promise of the project, while also reflecting the strength of collaboration between Eluceda and its academic partners. Eluceda extends its sincere thanks to: Prof. Gin Jose – Technical Adviser, for his invaluable expertise and guidance Dr. Ian Eastwood and Jack Eastwood – for their dedicated supervision and support The University of Leeds – for their ongoing partnership and collaboration Eluceda looks forward to advancing NanoTagg TM towards real-world adoption , furthering its mission to deliver cutting-edge solutions that safeguard industries and consumers worldwide.

SecuriTagg™ offers a crucial, unparalleled layer of security that traditional methods cannot match. Our range of advanced taggant solutions provides the Level 3 (Sophisticated Covert) - type security with the level 2-type teller assist simplicity combined with Level 4 (Forensic Security) protection, making it virtually impossible to detect with 'simple' verification tools. Click to download further information on SecuriTagg

Detection technology specialist Eluceda has developed a quick, accurate and easy-to-use testing solution for identifying counterfeit human growth hormone (hGH) without the need for centralised testing infrastructure. Existing drug authentication methods tend to rely on specialist, expensive, and centralised equipment with samples often having to travel across borders, leading to lengthy waits on test results. Rapid detection of genuine or counterfeit Somatropin based formulations is provided by Eluceda’s E-Sens™ testing device which can analyse the unique electrochemical ‘fingerprint’ of the hGH using electrochemical detection and providing results in less than a minute. Somatropin is used to treat serious growth hormone deficiencies in children, including pituitary dwarfism, Prader-Willi syndrome, Turner syndrome, as well as adult-onset growth hormone deficiencies, but is not always readily available to those without health insurance. As it increases muscle mass and skin thickness whilst reducing adipose tissue it has gained unsubstantiated popularity for anti-ageing purposes, body building and athletic performance enhancement making it prevalent on the black market through online web sales. At best, counterfeit drugs may contain the active pharmaceutical ingredient (API) but generally this is exceptional. Normally, to increase profits, counterfeits contain a lower dose of material, have a complete absence of API and are made in non-sterile conditions. Counterfeits are manufactured without any adherence to manufacturing regulations, pose health risks which lead to an increased morbidity and mortality. By providing rapid, cost-effective, and portable authentication technology that requires little training to use, Eluceda hopes to both improve confidence and safety in hGH use by helping to remove counterfeit drugs from the supply chain as quickly as possible. The new technology is explored in Eluceda’s latest White Paper which highlights results of trials where its E-Sens reader, when presented with counterfeit or adulterated medicines. Dedicated software records test data which can be uploaded to a database accessible by authorised stakeholders across the world. Other relevant data such as time, geolocation and information specific to the electrochemical ‘fingerprint’ are also logged, allowing for decentralised analysis and for trends to be identified quickly and efficiently. The test process involves inserting a small sensor into the E-Sens reader, which is connected to a mobile phone, tablet or PC, and dropping a small amount of liquid onto the sensor. These specialised sensors are designed to be disposable and are able to detect small variations in electrochemical signal, caused by dilution, contaminants, etc. “Counterfeit drugs are an increasing public health issue as people look to buy medicines online,” said Dr Ian Eastwood, CTO at Eluceda. “Somatropin is just one of many and by ensuring the products are genuine through our easy-to-use authentication technology we can help maintain confidence and protect the health of people worldwide.” The simplicity of Eluceda’s authentication solution allows for a diverse range of stakeholders to carry out authentication tests such as enforcement personnel, customs officials and medical professionals. For additional information about our latest news, please follow us across our Social Media platforms, LinkedIn , Twitter & Facebook .



